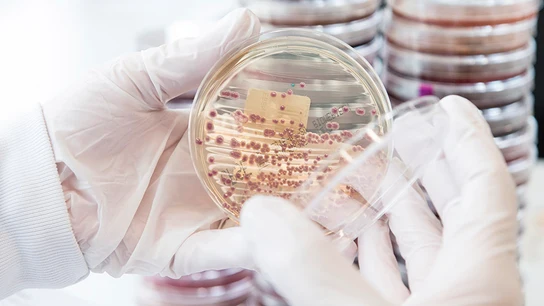

"Habrá más detalles"

"Habrá más detalles"

"Las cataratas más brutales que he visto en mi vida"

Según sondeos

Crisis migratoria

Mauritania, su primer destino

Inicio del curso político

África, la más afectada

Migración

Con 43 años
Piden adoptar medidas urgentes

Fue atacado tras grabar

10.000 militares portugueses muertos

Miedo al cólera

Colonialismo sanitario

Según un informe de Seguridad Nacional

Rusia gana influencia frente a la OTAN

Una experiencia única

Aventura